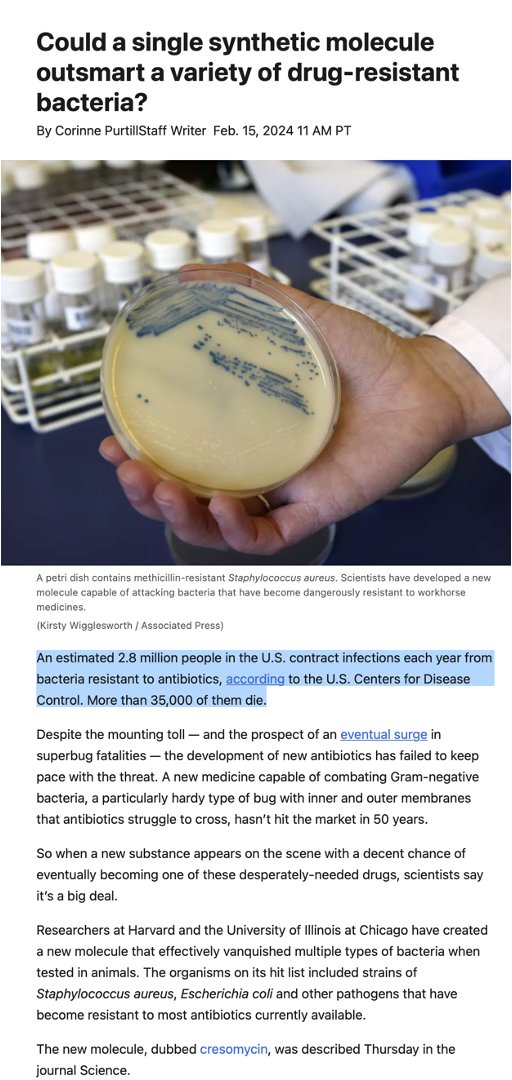

New Antibiotics 2024 List – The US economy is likely to reap considerable benefits from Americans taking popular medications used for weight loss such as Ozempic and Wegovy, Goldman Sachs analysts wrote in a recent research . AI has rapidly shifted from a “nice to have in the future” technology to the top priority for every health-tech’s R&D team. Bill Gates has spoken repeatedly about AI’s potential to save millions of .
New Antibiotics 2024 List
Source : twitter.comSave Antibiotics | Washington D.C. DC
Source : www.facebook.comEric Topol on X: “About 35,000 Americans are dying each year from
Source : twitter.comCompound Interest: A Brief Overview of Classes of Antibiotics
Source : www.compoundchem.comEric Topol on X: “About 35,000 Americans are dying each year from
Source : twitter.comComprehensive Panel & Novel Substance Expansion – Axis Forensic
Source : axisfortox.comList of Antibiotics | Download Table
Source : www.researchgate.netCompound Interest: A Brief Overview of Classes of Antibiotics
Source : www.compoundchem.comDiscovery, research, and development of new antibiotics: the WHO
Source : www.thelancet.comCould new antibiotic clovibactin beat superbugs? Or will it join
Source : theconversation.comNew Antibiotics 2024 List Eric Topol on X: “About 35,000 Americans are dying each year from : About three-quarters of Americans say they have heard a lot or a little about Ozempic, Wegovy and other similar drugs that are being used for weight loss. Among those familiar with these drugs, 53% . That all changed beginning in 2023, after the Biden administration capped out-of-pocket prescriptions at $3,500—no matter what drugs were needed. And this year, in 2024, the cap for all Medicare .
]]>